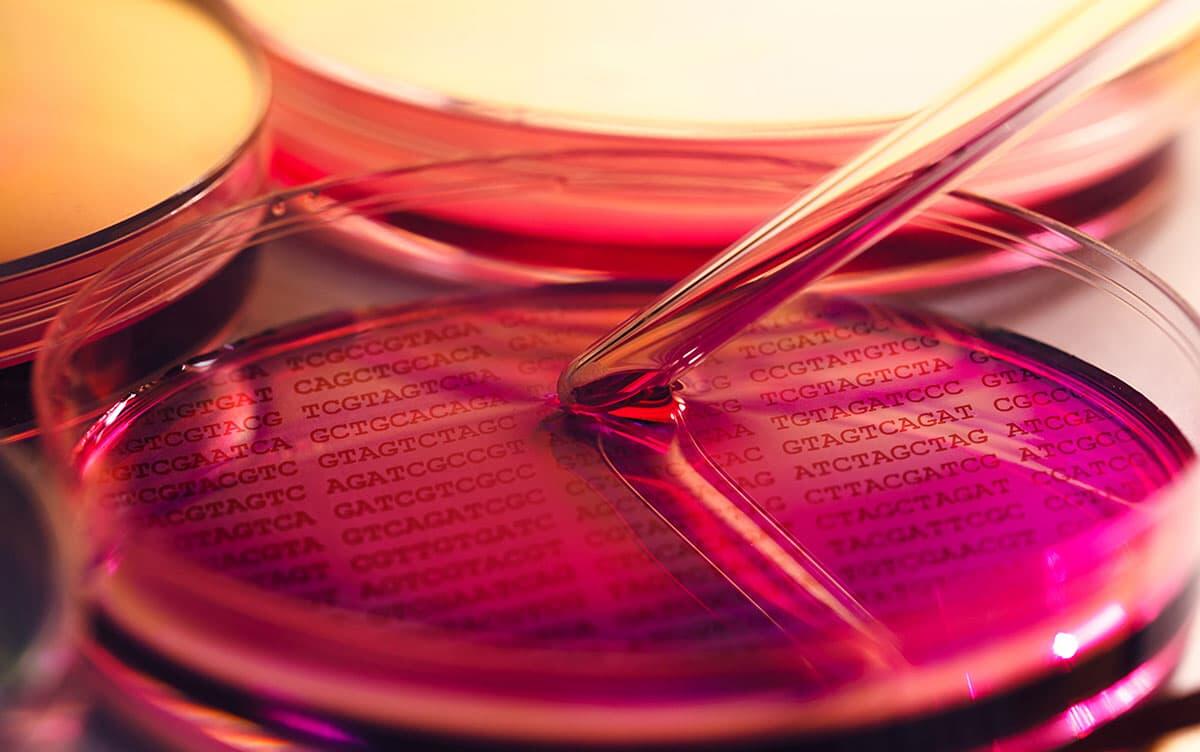
研究イメージ画像

生物・環境
細胞増殖において遺伝的変化と環境的変化の影響が相殺されることを発見
細胞増殖に影響する要因を探るため、細菌増殖時の細胞内遺伝子と細胞外の栄養環境のデータを用いて機械学習分析と相互作用解析を行いました。その結果、外部環境中の糖の量により増殖に影響する栄養成分が異なること、また、遺伝子の変化と栄養環境の変化は増殖への影響を相殺することを発見しました。
細胞の増殖は、遺伝的な要因と環境的な要因の両方に影響を受けます。これまで、それぞれの要因が増殖に与える影響は評価されてきましたが、両者を横断的に評価した例は少なく、これらの相互作用に関する知見は不足していました。本研究では、大規模な生物実験とデータ分析を組み合わせて、遺伝子と栄養(化学的な外部環境)の相互作用が細胞増殖に与える影響を探索しました。
48種類の栄養成分を組み合わせた135種類の栄養環境で、遺伝的に異なる115種類の大腸菌株を増殖させ、各条件での増殖の結果を定量的に測定することで、約14,000個のデータからなる大規模なデータセットを取得しました。このデータセットに機械学習分析を適用し、それぞれの菌株の増殖に最も影響を与える栄養成分を探ったところ、115種類の菌株が、外部環境中の糖の存在量によって、増殖の際に影響を受ける栄養成分が変化することを発見しました。さらに、理論的モデルによる相互作用パターン評価から、遺伝子の変化による増殖への影響と栄養環境の変化による増殖への影響は、互いに打ち消し合うことが明らかになりました。この相殺効果は、変化し続ける自然界を生き抜くための、細菌の一般的な特徴であると考えられます。
本研究成果は、細胞増殖に影響する要因に関する包括的な知見を与えるものであり、生命の普遍的な原理の解明だけでなく、細胞培養の最適化などの産業分野への貢献も期待されます。
PDF資料
プレスリリース研究代表者
筑波大学生命環境系應 蓓文 准教授
掲載論文
- 【題名】
-
Data-driven discovery of the interplay between genetic and environmental factors in bacterial growth
(細菌増殖における遺伝要因と環境要因の相互作用のデータ駆動型発見) - 【掲載誌】
- Communications Biology
- 【DOI】
- 10.1038/s42003-024-07347-3


